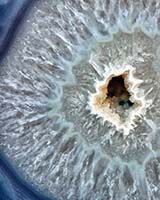

- SUBJECTS
- ARTISTS
- ROOMS
- BEST SELLER
Top Categories
- PRODUCT TYPES
Art on Demand
Photos to Art
Photo Frames

- PHOTOS TO ART
- DISCOVER
- BUSINESS & TRADE
Photography (11 items)
Active filter (remove all)

Sandro De Carvalho
AD-Lines
SDC-RC-1320B

Sandro De Carvalho
AD-Lines
SDC8-RC-059D

Sandro De Carvalho
AD-Lines
SDC8-RC-059C

Sandro De Carvalho
AD-Lines
SDC8-RC-059B

Sandro De Carvalho
AD-Lines
SDC8-RC-059A

Sandro De Carvalho
AD-Lines
SDC-RC-059D

Sandro De Carvalho
AD-Lines
SDC-RC-059C
Sandro De Carvalho
AD-Lines
SDC-RC-059B2

Sandro De Carvalho
AD-Lines
SDC-RC-059B

Sandro De Carvalho
AD-Lines
SDC-RC-059A2

Sandro De Carvalho
AD-Lines
SDC-RC-059A


















